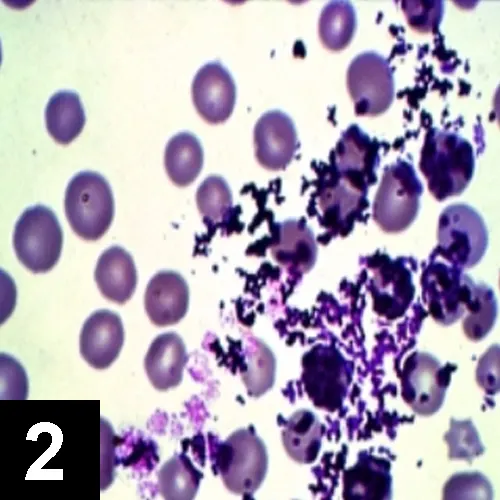
Featured Image
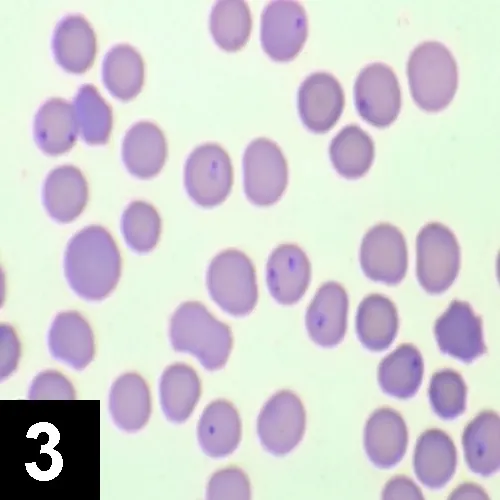
Featured Image

Feline Erythroparasites
Kimberly Caruso, DVM, Antech Diagnostics, Irvine, CA

Blood smear from the patient
Signalment
A 6-year-old, neutered male domestic shorthair cat presents to your veterinary hospital with a history of acute lethargy.
History
The owner reports that the cat appeared normal the day before. She doubts that the cat had access to poisons and does not administer flea or tick control products. The cat is an indoor-outdoor cat, vaccinations are up-to-date, and it has had no previous medical problems. The cat has not been vomiting, coughing, or sneezing and has not had diarrhea; it has not traveled anywhere recently. The cat is fed a high-quality maintenance diet, but became inappetant on the day of presentation. The owner also thinks the animal may be having difficulty breathing.


Physical Examination Findings
The cat appears quiet and weak but is alert. Mucous membranes are pale pink; temperature is 103.6° F, respiration 60 breaths/minute, and heart rate 240 beats/minute. The cat is tachypneic with increased bronchovesicular sounds bilaterally and a grade-1 heart base murmur that seems holosystolic in nature. No wheezes, crackles, or areas of dullness can be detected. The heart is easily audible. Lymph nodes and abdominal palpation are normal.
Initial Diagnostic Testing
A blood sample was taken from the jugular vein and placed in a red-topped serum tube and a purple-topped EDTA tube for serum biochemistry and CBC profile, respectively. Two blood smears were also made and sent STAT along with the blood samples to the local veterinary laboratory. The veterinarian saved a smear to examine pending blood results and pathologist review of the blood smear. Within an hour, the blood results were available but the pathologist's review was pending. The results are shown in the tables.
What can be learned from the CBC and serum biochemistry results?
The cat is severely anemic as shown by the decreased PCV, red blood cell count, and hemoglobin values. The anemia appears regenerative given the polychromasia and nucleated red blood cells reported. Total bilirubin can be elevated with hemolysis (prehepatic), liver disease (hepatic), and cholestasis (posthepatic). Alanine transaminase and aspartate transaminase levels as well as the inducible cholestatic enzymes alkaline phosphatase and γ-glutamyltransferase are within normal limits. Therefore, the regenerative anemia is probably secondary to hemolysis. This is supported by the normal albumin levels, which are often decreased with hemorrhage (i.e., except for internal bleeding).
You examine the blood smear (Figure 1) that you saved pending the pathologist's review and describe your findings as follows: You agree that the smear appears thin, a finding consistent with anemia. The number of leukocytes appears to be within normal limits. On higher power (1000×), you observe polychromasia with occasional nucleated red blood cells (metarubricytes mainly), which supports the diagnosis of regenerative anemia. This would be confirmed with a reticulocyte count. Platelets appear adequate (8 to 12/high-power field). On closer evaluation of the red blood cells, you notice small, reddish organisms that are approximately 0.5 μm in diameter and cocci-shaped. They appear individually as well as in short chains on the red blood cell membrane surface and in the background.

What is your diagnosis of the cause of anemia?
Haemobartonella felis, now reclassified as Mycoplasma haemofelis infection of the red blood cells, is considered the definitive diagnosis. These mycoplasma are pleomorphic bacteria that act as erythroparasites that attach themselves to the surface of the red blood cell. They can appear as rod-, cocci-, or ring-shaped organisms present individually or in chains on the surface of the red blood cell. Cats have intermittent (cyclic) parasitemias with chronic infections, so organisms may not always be detected in peripheral blood. A smaller Mycoplasma species (Mycoplasma haemominutum) has been reported but is associated with minimal or mild clinical signs.
What clinical signs are associated with infection of Mycoplasma haemofelis?
Lethargy, anorexia, fever, and regenerative anemia. Splenomegaly and icterus are variable; the latter is usually absent. The acute hemolytic anemia associated with this erythroparasite may be fatal. PCV as low as 11% is commonly reported.
How is Mycoplasma haemofelis transmitted?
The infection is transmitted by blood-feeding arthropods (often fleas), cat bites, and blood transfusions. In addition, the organisms can be transmitted in utero, at parturition, and via nursing by neonates of infected queens.
What artifact can mimic these erythroparasites on a stained blood smear?
Stain precipitate can mimic these erythroparasites (Figure 2). Be sure to change your stains frequently (i.e., every 2 weeks). Stain precipitate is typically not in the same plane of focus as the erythroparasites, and this may help to differentiate between these processes. Always have the blood smear confirmed by a clinical pathologist at your local veterinary laboratory.
Why did the veterinarian make a direct blood smear on collection of the blood to send in along with the sample in EDTA?
Mycoplasma organisms are epicellular and may fall off the red blood cells in aged samples; they may thus go undetected by the laboratory if just an EDTA tube of blood is sent. In addition, it precludes artifacts caused by the aging that occurs in transit, thereby facilitating the pathologist's review.
What other methods can be used to detect suspected Mycoplasma haemophilus infection when the organisms cannot be detected in peripheral blood?
Polymerase chain reaction is a sensitive test that amplifies a particular DNA sequence from the organism in vitro. Contact your laboratory regarding blood sample submission.
Is Mycoplasma haemofelis treatable?
Yes. Doxycycline 2.5 to 5 mg/kg orally Q 12 H for 3 weeks is recommended as an effective antimicrobial treatment for infection with hemobartonellosis.
Another Scenario
Let's change the scenario slightly. What if the cat presented with severe acute icterus, lethargy, fever, hepatomegaly, and splenomegaly and died shortly after presentation to the clinic? Say that you live in the Midwest or southern United States. Before the animal died, you were able to take just enough blood to make a blood smear and obtain a PCV, which was 10%.
Look at Figure 3 to observe the blood smear.
What do you observe?
The smear is thin, indicative of severe anemia. No evidence of polychromasia is noted, thereby supporting a diagnosis of nonregenerative/preregenerative anemia. Only a few white blood cells are present, indicative of leukopenia. Platelets appear decreased. In addition, signet ring-shaped organisms (piroplasms) approximately 1 to 2 μm in diameter are noted with the erythrocytes.
Why did the animal die?
Cytauxzoon felis infection, an intracellular protozoan erythroparasite transmitted by the tick Dermacentor variabilis, is the definitive diagnosis. Cats are accidental hosts; bobcats are reservoir hosts. Although the disease is rarely fatal in bobcats, it is usually fatal in domestic cats. To date, no effective treatment has been developed. Survival in cats with a less virulent form of _Cytauxzoon feli_s has been reported.
How do clinical signs of cytauxzoonosis differ from those of Mycoplasma haemofelis?
The cats typically present with acute severe icterus, fever, mild to moderate hemolytic nonregenerative anemia, neutropenia with a degenerative left shift, and thrombocyto-penia. Splenomegaly, hepatomegaly, and lymphadenopathy are also common (i.e., secondary to the tissue stage, schizonts are found within macrophages in these tissues). Acute death is common.